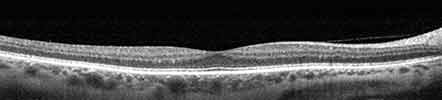
healthy retina photo

Vision-threatening diseases often have no outward signs or symptoms in the early stages, so our practice has begun using state-of-the-art technology to assess the health of your eyes.
The OCT Exam is a quick, non-invasive scan that allows our doctors to see all 10 layers of your retina. The Clarus retinal camera gives a view into the periphery of your eye normally not accessible without a dilated pupil.
As part of your pre-testing, our technician will perform the OCT and Clarus Wide Field Retinal Photo Exam which your doctor will review with you during your examination today. The charge of $44 is typically not covered by your vision or medical insurance, so this will be added to the cost of your visit today.
Thank you for choosing our practice to protect the health of your eyes!
Eye Wellness Exam Examples
Healthy Retina Unhealthy Retina

If you choose not to have your eyes dilated because of the possibility of blur and light sensitivity, our doctors would strongly suggest you to have a wider view photo of the back of your eye.
 Diabetic Retinopathy
Diabetic Retinopathy  Macular Degeneration
Macular Degeneration  Glaucoma
Glaucoma
